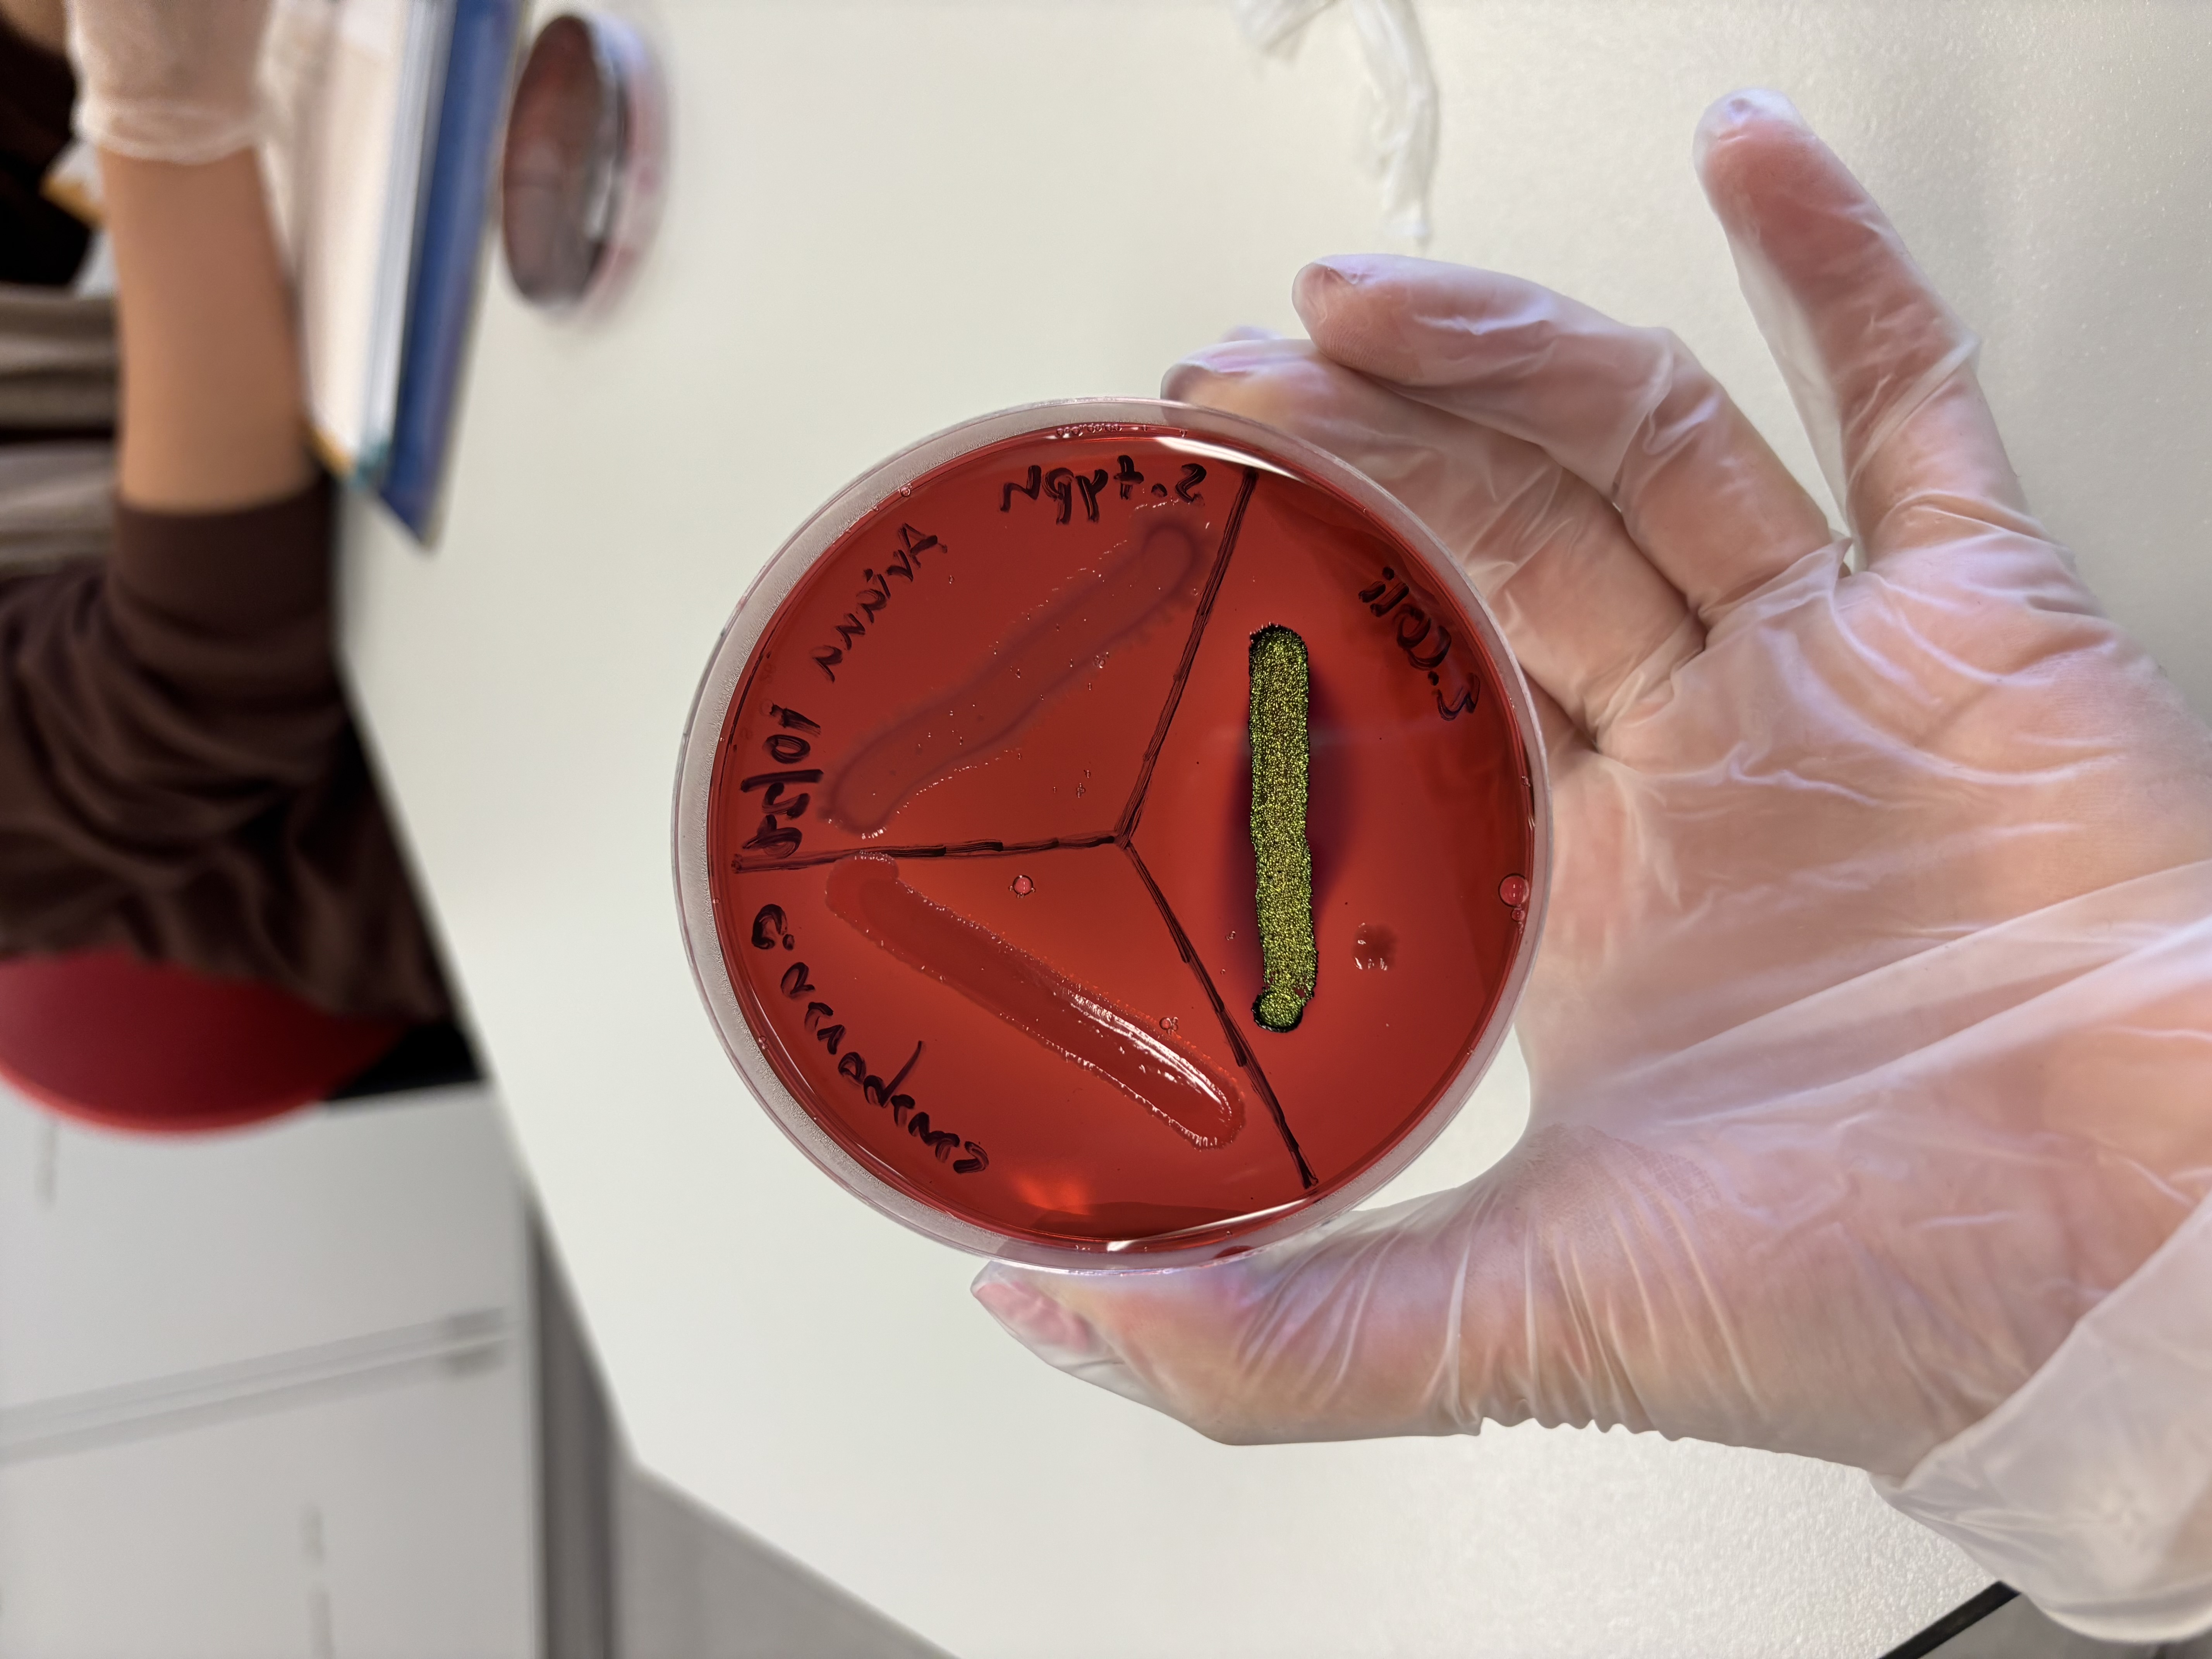
<p><strong>Positive:</strong></p><ul><li><p>Metallic green sheen (strong fermenter)</p></li><li><p>Purple/dark colonies (moderate fermenter)<br><strong>Meaning:</strong> Lactose fermentation<br><strong>Example:</strong> <em>E. coli</em></p></li></ul><p></p>

1/11
Looks like no tags are added yet.
Name | Mastery | Learn | Test | Matching | Spaced | Call with Kai |
|---|
No analytics yet
Send a link to your students to track their progress
Phenol Red Broths (Dex, Suc, Lac)
Positive: Yellow (acid) ± bubble (gas)
Meaning: Fermentation of the sugar

MacConkey Agar (MAC)
Positive: Pink colonies (lactose fermenter)
Strong positive: Hot pink precipitate
Meaning: Gram-negative lactose fermentation
EMB Agar
Positive:
Metallic green sheen (strong fermenter)
Purple/dark colonies (moderate fermenter)
Meaning: Lactose fermentation
Example: E. coli
Methyl Red (MR)
Positive: Bright red color
Meaning: Mixed-acid fermentation

Voges-Proskauer (VP)
Positive: Pink/red color after reagents
Meaning: Acetoin (2,3-butanediol pathway)

Phenylalanine Deaminase (Phe)
Positive: Green color with FeCl₃
Meaning: Phenylalanine deaminase produced
Examples: Proteus, Morganella, Providencia

Citrate Test
Positive: Blue slant (or growth with blue)
*slant is originally green
Meaning: Citrate used as sole carbon source

LIA (Lysine Iron Agar)
Positive Reactions:
Purple butt → Lysine decarboxylase
Red slant → Lysine deamination
Black → H₂S

Urea Broth
Positive: Hot pink (fuchsia)
Meaning: Urease enzyme active
TSI (Triple Sugar Iron)
Positive Indicators:
A/A (yellow slant & butt) → glucose + lactose/sucrose fermentation
K/A (red slant, yellow butt) → glucose only
Black → H₂S
Bubbles/cracks → gas

MIO (Motility, Indole, Ornithine)
Motility Positive: Cloudy growth beyond stab
Indole Positive: Red ring with Kovac’s reagent
Ornithine Positive: Tube turns purple
Oxidase Test
Positive: Dark purple within 30 sec
Meaning: Cytochrome c oxidase present
Examples: Pseudomonas, Neisseria
